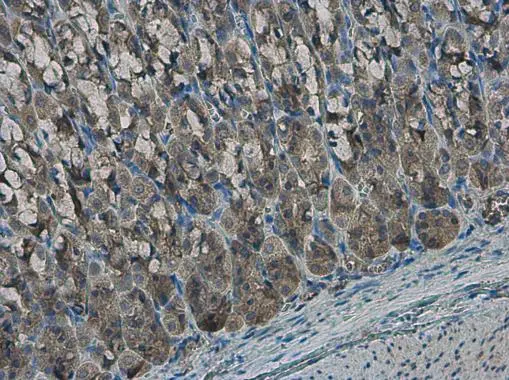
EFHA1 antibody detects EFHA1 protein at cytoplasm in rat stomach by immunohistochemical analysis. Sample: Paraffin-embedded rat stomach. EFHA1 antibody (GTX118555) diluted at 1:500. 
 Antigen Retrieval: Citrate buffer, pH 6.0, 15 min

EFHA1 antibody detects EFHA1 protein at cytoplasm in rat colon by immunohistochemical analysis. Sample: Paraffin-embedded rat colon. EFHA1 antibody (GTX118555) diluted at 1:500.
Antigen Retrieval: Citrate buffer, pH 6.0, 15 min
EFHA1 antibody
GTX118555
ApplicationsImmunoHistoChemistry, ImmunoHistoChemistry Paraffin
Product group Antibodies
ReactivityHuman, Mouse, Rat
TargetMICU2
Overview
- SupplierGeneTex
- Product NameEFHA1 antibody
- Delivery Days Customer9
- Application Supplier NoteIHC-P: 1:100-1:1000. *Optimal dilutions/concentrations should be determined by the researcher.Not tested in other applications.
- ApplicationsImmunoHistoChemistry, ImmunoHistoChemistry Paraffin
- CertificationResearch Use Only
- ClonalityPolyclonal
- Concentration1.55 mg/ml
- ConjugateUnconjugated
- Gene ID221154
- Target nameMICU2
- Target descriptionmitochondrial calcium uptake 2
- Target synonyms1110008L20Rik, EFHA1, hMICU3, calcium uptake protein 2, mitochondrial, EF hand domain family A1, EF hand domain family, member A1, EF-hand domain-containing family member A1, Smhs2 homolog
- HostRabbit
- IsotypeIgG
- Protein IDQ8IYU8
- Protein NameCalcium uptake protein 2, mitochondrial
- ReactivityHuman, Mouse, Rat
- Storage Instruction-20°C or -80°C,2°C to 8°C
- UNSPSC12352203